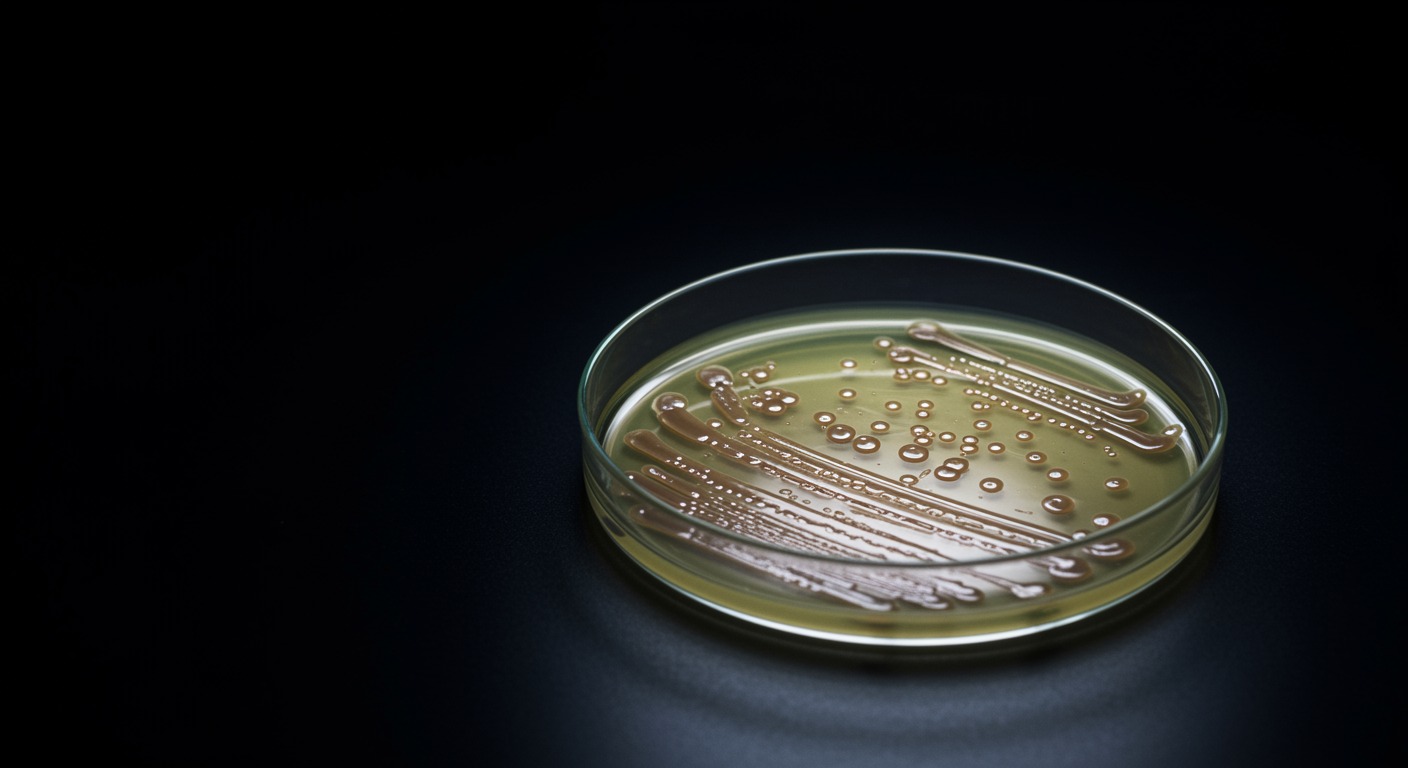
Single petri dish with bacterial culture under laboratory lighting

What did Fleming’s original penicillin paper actually discover?
Fleming’s 1929 paper documented that Penicillium notatum mold produced a substance that killed staphylococci and streptococci, but he primarily saw it as a laboratory tool rather than a therapeutic breakthrough. This foundational paper established penicillin’s antibacterial properties but underestimated its world-changing potential.
Fleming's original observations were methodical and precise. He documented the "zone of inhibition" around mold colonies, tested the filtered broth against various bacteria, and noted that the substance was non-toxic to white blood cells. However, he focused mainly on penicillin's potential for isolating certain bacteria in laboratory cultures, not as a treatment for human infections.This paper represents the exact moment described in the penicillin podcast - the accidental discovery that would change medicine forever. Fleming’s contaminated petri dish became the foundation for the Oxford team’s later work and the massive wartime production effort. Yet reading the original paper reveals how close this discovery came to remaining a laboratory curiosity.
What the data show:
- Broad antibacterial activity: Penicillin inhibited staphylococci, streptococci, pneumococci, and gonococci while sparing most gram-negative bacteria
- Remarkable potency: The filtered broth remained active even when diluted 1 in 800, demonstrating significant antibacterial strength
- Non-toxic properties: Unlike chemical antiseptics, penicillin showed no toxicity to white blood cells or tissue cultures
- Stability limitations: The substance was unstable, losing activity within days to weeks, which limited Fleming’s ability to pursue therapeutic applications
This landmark paper, published in the British Journal of Experimental Pathology, represents the first scientific documentation of penicillin’s properties and established the foundation for all subsequent antibiotic research.
Dr. Kumar’s Take
Reading Fleming’s original paper is fascinating because it captures both the brilliance and limitations of the discovery. Fleming clearly recognized he had found something remarkable - a non-toxic substance that could kill dangerous bacteria. His experimental design was meticulous, and his observations were accurate.
What’s striking is how he underestimated the therapeutic potential. Fleming focused on penicillin’s laboratory applications, particularly for isolating Haemophilus influenzae by suppressing other bacteria. He briefly mentioned possible therapeutic uses but didn’t pursue them aggressively. This shows how even groundbreaking discoveries can be limited by the discoverer’s perspective and available resources. It took the Oxford team’s different approach and wartime urgency to unlock penicillin’s true potential.
Historical Context
In 1928, Fleming was investigating lysozyme, a natural antibacterial substance found in tears and saliva. His laboratory work involved growing staphylococci on culture plates to test various substances for antibacterial activity. The accidental contamination that led to penicillin’s discovery occurred during this routine research.
Fleming’s laboratory was known for being somewhat disorganized, which ironically contributed to the discovery. Had he been more meticulous about preventing contamination, the mold spores might never have landed on his bacterial cultures. The discovery required both accident and acute observation.
What the Research Shows
Fleming’s paper systematically documented penicillin’s properties through careful experimentation:
The Discovery Process Fleming observed that bacterial growth was inhibited around mold colonies that had accidentally contaminated his culture plates. He isolated the mold, identified it as Penicillium notatum, and grew it in broth culture to produce the active substance.
Antibacterial Spectrum Testing showed that penicillin was highly effective against gram-positive bacteria including staphylococci, streptococci, pneumococci, and gonococci. However, it had little effect on gram-negative bacteria like E. coli or Salmonella, establishing the selective spectrum that remains characteristic of penicillin today.
Potency and Safety The filtered mold broth remained active at dilutions up to 1 in 800, demonstrating remarkable potency. Crucially, Fleming found that concentrations effective against bacteria showed no toxicity to white blood cells or tissue cultures, suggesting therapeutic potential.
Stability Challenges Fleming noted that penicillin was unstable, losing activity within days to weeks. This instability, combined with low yields from his culture methods, prevented him from pursuing large-scale production or extensive therapeutic testing.
Laboratory Applications Fleming primarily promoted penicillin’s use for selective bacterial isolation, particularly for growing Haemophilus influenzae by suppressing competing bacteria in clinical specimens.
Practical Takeaways
- Observation skills matter: Fleming’s ability to notice and investigate an “accident” led to one of medicine’s greatest discoveries
- Initial applications may not reveal full potential: Fleming saw penicillin as a laboratory tool, not realizing its therapeutic possibilities
- Technical limitations can delay breakthroughs: Instability and low yields prevented Fleming from fully developing penicillin’s potential
- Collaboration amplifies discovery: Fleming’s observation required the Oxford team’s expertise to become a practical medicine
Related Studies and Research
- Penicillin: The Accidental Discovery That Changed Medicine and Won a War
- The Discovery of Penicillin: New Insights After More Than 75 Years
- Penicillin: The Oxford Story
- How Penicillin Was Discovered in the 20th Century in Oxford
FAQs
How exactly did Fleming discover penicillin?
Fleming noticed that bacterial growth was inhibited around mold colonies that had accidentally contaminated his staphylococcal culture plates. Instead of discarding the contaminated plates, he investigated the phenomenon and isolated the active substance.
Why didn’t Fleming develop penicillin as a medicine immediately?
Fleming faced technical challenges including penicillin’s instability and low production yields. He also lacked the biochemical expertise and resources needed for large-scale purification and testing. His focus remained on laboratory applications rather than therapeutic development.
What bacteria does penicillin work against according to Fleming’s original paper?
Fleming found penicillin effective against gram-positive bacteria including staphylococci, streptococci, pneumococci, and gonococci. It showed little activity against gram-negative bacteria like E. coli, establishing the selective spectrum still characteristic of penicillin.
How did Fleming test penicillin’s safety?
Fleming tested penicillin’s effects on white blood cells and tissue cultures, finding no toxicity at concentrations that killed bacteria. This suggested therapeutic potential, though he didn’t pursue extensive animal or human testing.
Bottom Line
Fleming’s original penicillin paper represents one of medicine’s most important publications, documenting the discovery that would eventually save millions of lives. While Fleming recognized penicillin’s antibacterial properties and non-toxic nature, he primarily saw it as a laboratory tool rather than a therapeutic breakthrough. The paper’s true significance became apparent only when the Oxford team later developed Fleming’s observation into a practical medicine, showing how scientific discoveries often require multiple perspectives and collaborative effort to reach their full potential.